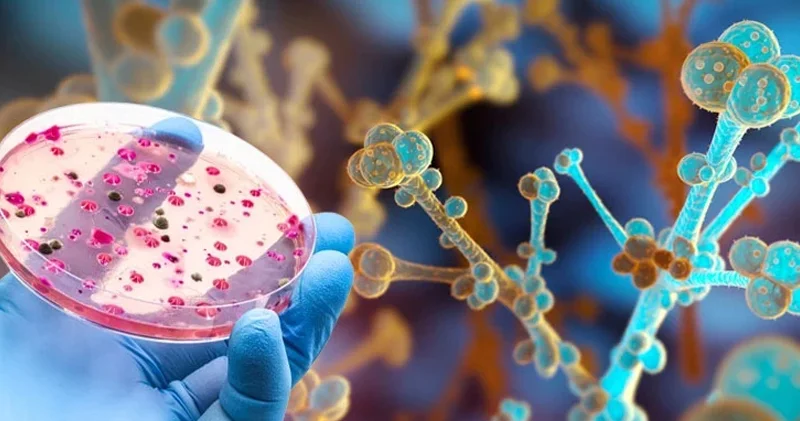
Dünyada ölümcül bir göbələk yayılır: 6 qitədə 6,5 milyon insan

“Sənətkarın dostu” layihəsinin növbəti qonağı Xalq artisti Əlixan Səmədov olub AZƏRTAC
Icma.az, Azertag saytından verilən məlumata əsaslanaraq xəbər yayır.
Bakı, 27 dekabr, AZƏRTAC
Mədəniyyət üzrə Elmi-Metodiki və İxtisasartırma Mərkəzinin təşkilatçığı, Bakı şəhər Mədəniyyət Baş İdarəsinin dəstəyi ilə “Sənətkarın dostu” layihəsi çərçivəsində növbəti görüş Georgi Şaroyev adına 35 nömrəli onbirillik musiqi məktəbində keçirilib.
Mərkəzdən AZƏRTAC-a bildirilib ki, Dünya Azərbaycanlılarının Həmrəyliyi Gününə həsr olunmuş görüşün qonağı balaban ifaçısı, Xalq artisti Əlixan Səmədov olub.
Tədbirdə AZAL şirkətinə məxsus Bakı-Qroznı istiqamətində uçan sərnişin təyyarəsinin qəzaya uğraması nəticəsində həlak olanların xatirəsi bir dəqiqəlik sükutla yad edilib.
Mərkəzin direktor vəzifəsini icra edən Vüqar Hümbətov, Bakı şəhər Mədəniyyət Baş İdarəsinin rəisi İbrahim Əliyev və musiqi məktəbinin direktoru Vəfa Həziyeva layihənin əhəmiyyətindən danışıblar.
Əlixan Səmədov 60 illik yubileyi ərəfəsində baş tutmuş görüşdə həyat və yaradıcılığı, balaban ifaçılığı sənəti, pedaqoji fəaliyyəti, uşaq və gənclərin nəfəs alətlərinə marağının artırılması və xaricdə yaşayan Azərbaycan mədəniyyət xadimlərinin fəaliyyəti istiqamətində söhbət aparıb. Ustad balaban haqqında yazdığı kitabından bəhs edərək milli musiqimizin müəllif hüquqlarının qorunması zərurətindən, həmçinin müasir təbliğat və təşviqat vasitələrindən danışıb.
Sənətkar və musiqi məktəbinin IX sinif şagirdləri musiqi əsərləri ifa ediblər.
Ustad dərsi formatında keçirilmiş tədbirin sonunda iştirakçıları maraqlandıran suallar cavablandırılıb.
Qeyd edək ki, “Sənətkarın dostu” layihəsi mədəniyyətin təşviqi, uşaq və gənclərin yaradıcılığının stimullaşdırılması, görkəmli mədəniyyət xadimləri ilə gənc istedadların zəngin təcrübə mübadiləsinin təşkili məqsədilə həyata keçirilir.
 Bu mövzuda digər xəbərlər:
Bu mövzuda digər xəbərlər: Baxış sayı:147
Baxış sayı:147 Bu xəbər 27 Dekabr 2024 16:07 mənbədən arxivləşdirilmişdir
Bu xəbər 27 Dekabr 2024 16:07 mənbədən arxivləşdirilmişdir



 Daxil ol
Daxil ol
 Online Xəbərlər
Online Xəbərlər Xəbərlər
Xəbərlər Hava
Hava Maqnit qasırğaları
Maqnit qasırğaları Namaz təqvimi
Namaz təqvimi Kalori kalkulyatoru
Kalori kalkulyatoru Qiymətli metallar
Qiymətli metallar Valyuta konvertoru
Valyuta konvertoru Kredit Kalkulyatoru
Kredit Kalkulyatoru Kriptovalyuta
Kriptovalyuta Bürclər
Bürclər Sual - Cavab
Sual - Cavab İnternet sürətini yoxla
İnternet sürətini yoxla Azərbaycan Radiosu
Azərbaycan Radiosu Azərbaycan televiziyası
Azərbaycan televiziyası Haqqımızda
Haqqımızda



 TDSMedia © 2026 Bütün hüquqlar qorunur
TDSMedia © 2026 Bütün hüquqlar qorunur








 Günün ən çox oxunanları
Günün ən çox oxunanları